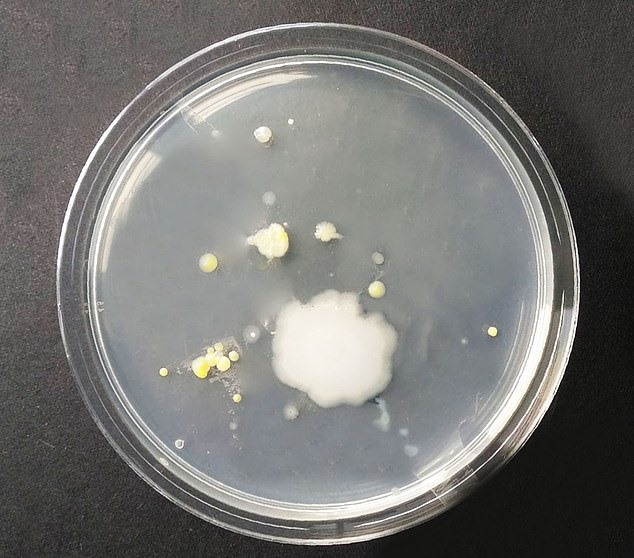
Mầm bênh - nấm men sinh sôi trên ti giả của trẻ em khi để trong ô tô. Ảnh: Daily Mail.
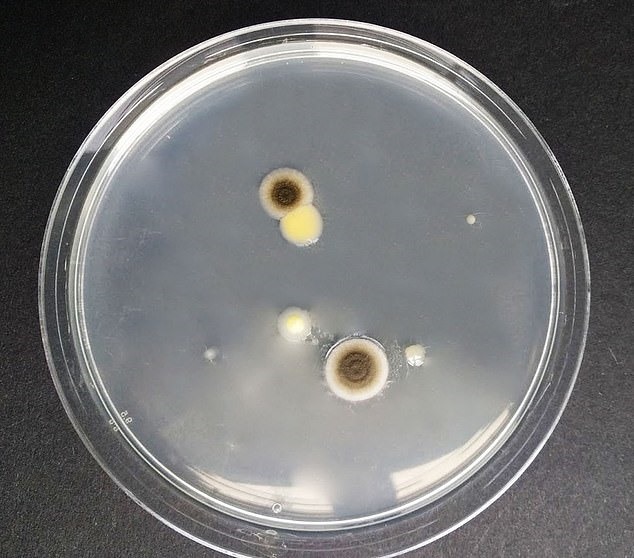
Mầm bệnh - nấm mốc phát triển lan rộng dần trên hóa đơn sau 5 ngày để trong xe ô tô. Ảnh: Daily Mail.

Xe cộ
03/09/2020 05:12Thủ phạm bất ngờ giấu mầm bệnh sinh sôi trong ôtô của bạn
Một nghiên cứu được thực hiện bởi nhóm vi sinh vật tại Đại học London Metropolitan (Anh) đã phát hiện ra rằng, các vật dụng để trong ôtô là nơi sinh sản hoàn hảo của những mầm bệnh nguy hiểm chỉ sau vài ngày, Daily Mail đưa tin.
Dù tháng 7 vừa qua không quá nóng, nhưng nhiệt độ bên trong xe ôtô lên tới 33 độ C - cao hơn cả nhiệt độ trung bình mùa hè ở Hy Lạp.
Những mầm bệnh bắt đầu sinh sôi trên 16 vật dụng trong vòng vài ngày, trong đó đặc biệt phải kể đến kính râm, túi nilon, ti giả cho trẻ em và hóa đơn.
Đáng ngạc nhiên, thử nghiệm cho thấy những đồ không phải thực phẩm thường được để trong xe nhiều ngày tạo ra nhiều vi khuẩn hơn bao bì thực phẩm và đồ uống.
Đặc biệt đối với kính râm, khi để trong xe vài ngày với nhiệt độ ấm áp, kính râm bị nhiễm vi khuẩn Staphylococcus epidermidis - có thể gây nhiễm trùng.
![]() |
| Khi để trong xe ôtô hai ngày, cặp kính râm được kiểm tra đã bắt đầu tích tụ mầm bệnh và bị nhiễm Staphylococcus epidermidis rất cao. Ảnh: Daily Mail. |
Đối với túi nilon, trên bề mặt hình thành loại nấm mốc xanh độc hại, cực kỳ nguy hiểm cho những người có vấn đề về hô hấp. Việc ăn phải nấm mốc còn gây hại đặc biệt cho những người bị hen suyễn hoặc dị ứng.
![]() |
| Mầm bệnh - loại nấm mốc xanh độc hại đã bắt đầu tích tụ trên túi nilon sau 2 ngày để trong ô tô. Ảnh: Daily Mail. |
Thường được dùng để dỗ trẻ em, ti giả được nhiều bậc phụ huynh coi là vật hỗ trợ đắc lực. Tuy nhiên, việc để ti giả lâu dài trong xe ôtô khiến đồ vật này có thể xuất hiện 1 loại nấm men - nguyên nhân phổ biến khiến trẻ bị nấm miệng.
![]() |
| Mầm bênh - nấm men sinh sôi trên ti giả của trẻ em khi để trong ôtô. Ảnh: Daily Mail. |
Dù có thể điều trị bằng thuốc, các nhà khoa học khuyến cáo chỉ nên cho trẻ ngậm ti giả khi trẻ ở trong nhà. Ngoài ra, cần vứt bỏ khi đã để ti giả trong ôtô mà không bao giờ cho trẻ sử dụng tiếp.
![]() |
| Mầm bệnh - nấm mốc phát triển lan rộng dần trên hóa đơn sau 5 ngày để trong xe ô tô. Ảnh: Daily Mail. |
Hóa đơn có lẽ là một trong những thủ phạm khá bất ngờ đối với nhiều người. Vài ngày bỏ trong ôtô, những tờ giấy tưởng chừng vô hại này phát triển nấm mốc có thể tạo ra các chất độc hại gây kích ứng, dị ứng và hen suyễn. Vì vậy, nên bỏ chúng đi nếu bạn không cần tới nữa.
Ngoài những đồ vật trên, đồ chơi cho thú cưng, quần áo hay giày tập thể dục, tiền xu, muỗng ăn kem, cốc giấy đựng cafe, chai nhựa đựng nước, giấy gói bánh cũng là "thủ phạm" sinh sôi mầm bệnh nguy hiểm trên xe ôtô.
Lê Thanh Hà
- Nga khôi phục hoạt động hàng không miền Nam sau các vụ tấn công bằng UAV (1 giờ trước)
- Đội tuyển Iran chốt quyết định cuối cùng về việc dự World Cup 2026 (1 giờ trước)
- Vi phạm nồng độ cồn, tài xế đâm xe chuyên dụng của CSGT chạy trốn (1 giờ trước)
- Xuất hiện cá heo trắng quý hiếm tung tăng trên vùng biển Đồ Sơn (2 giờ trước)
- V.League 2025 - 2026: Sân chơi của các huấn luyện viên ngoại?! (2 giờ trước)
- Iran chặn tàu của nước ủng hộ Mỹ qua eo biển Hormuz (3 giờ trước)
- Điều tra vụ người đàn ông phá hoại tài sản trên cao tốc Bắc - Nam (3 giờ trước)
- Cháy lớn công ty dệt may ở Đồng Nai, cột khói bốc cao hàng trăm mét (5 giờ trước)
- Tàu chở dầu đầu tiên của Qatar vượt eo biển Hormuz kể từ khi xung đột bắt đầu (5 giờ trước)
- Quốc gia đồng minh bất ngờ từ chối cho máy bay Mỹ qua không phận để hộ tống tàu dầu: Chiến lược của Nhà Trắng bị nghi ngờ? (7 giờ trước)